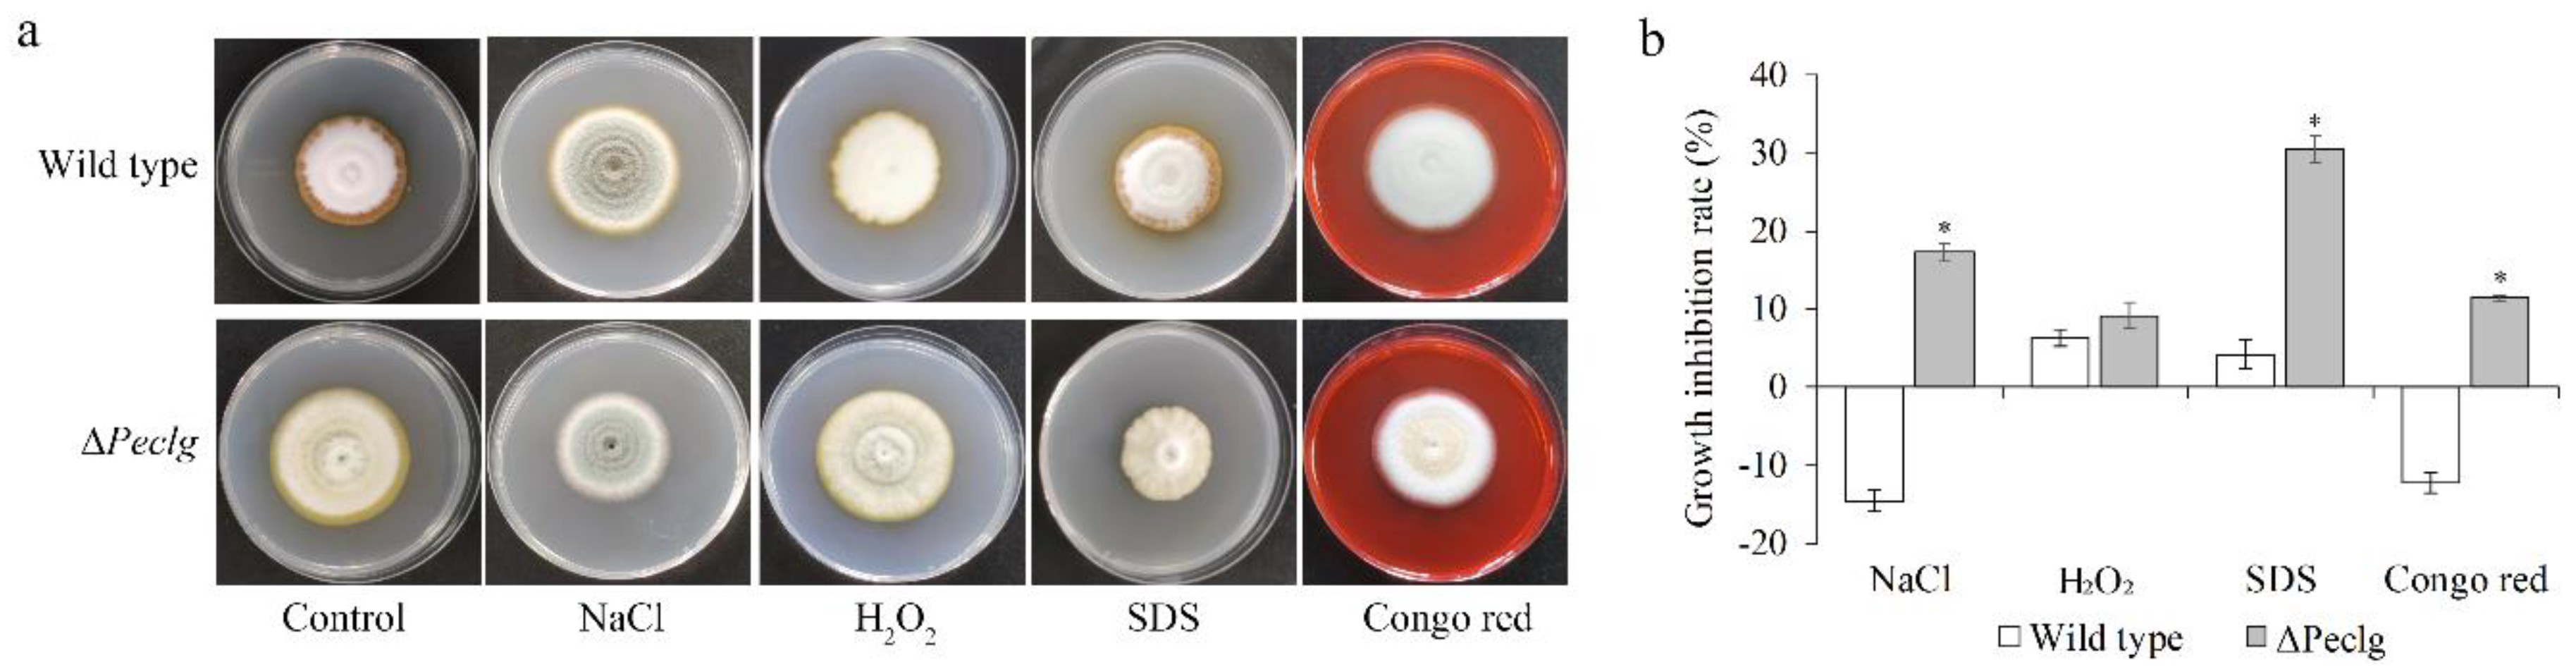
Foods 12 00479 g004 Foods 12 00479 g004

Abstract
Penicillium expansum is the causal agent of blue mold decay on apple fruits and is also known to be the major producer of patulin, a mycotoxin that represents serious hazard to human health. Several mechanisms have been suggested to explain the pathogenesis of P. expansum in host plants. Secreted effector proteins are vital for the pathogenicity of many fungal pathogens through manipulating their hosts for efficient colonization. In this study, we performed a RNA-Seq analysis followed by computational prediction of effector proteins from P. expansum during infection of the host apple fruits, and a total of 212 and 268 candidate effector protein genes were identified at 6 and 9 h after inoculation (hai), respectively. One of the candidate effector protein genes was identified as a concanavalin A-like lectin/glucanase (Peclg), which was dramatically induced during the pathogen–host interaction. Targeted knockout of Peclg resulted in significant reduction in conidial production and germination relative to the wild type. Further studies showed that in addition to salt stress, the mutant was much more sensitive to SDS and Congo red, suggesting a defect in cell wall integrity. Pathogenicity assays revealed that the ΔPeclg mutant showed significant decrease in virulence and infectious growth on apple fruits. All these results suggest that Peclg is required for fungal growth, stress response, and the virulence of P. expansum.
1. Introduction
Penicillium expansum is the major causal agent of blue mold decay, which is known to be one of the most common postharvest diseases of apple fruits. In addition to causing significant economic losses worldwide, P. expansum also produces harmful mycotoxins, such as patulin, which is detrimental to human health and is also a potential carcinogen [1,2]. Due to the lack of host-based resistance to blue mold disease in commercial apple cultivars, chemical fungicides remain the primary strategy in the control of postharvest decay. However, as a result of their widespread use, fungicide-resistant populations of this pathogen have emerged, and most chemicals now have reduced efficacy to control blue mold decay of apple fruit [3,4]. Hence, innovative approaches are needed to develop new and more effective control strategies. Exploring the virulence determinants and understanding the molecular mechanisms of pathogenicity of P. expansum, which has been greatly accelerated by the releasing of the genomic sequence of this fungus [5,6], might lead to new mitigation strategies for postharvest blue mold decay.
While some postharvest pathogenic fungi can infect host plants directly, others such as P. expansum, an opportunistic fungus, infects fruit through natural opening or wounds inflicted before, during, and after harvest [7,8]. To successfully infect and colonize host plants, numerous virulence strategies have evolved in fungal pathogen to suppress the plant innate immune response, manipulate host physiology to accommodate microbial invaders, and thereby promote infection and disease development [9,10]. Among these strategies, a broad spectrum of secreted virulence factors is at the front line of host–microbe interactions, and these play important roles in plant infection [11,12].
During the past decade, many efforts have been made to identify effectors that contribute to the virulence of P. expansum [13]. For example, a series of works by Levin et al. [14,15] revealed that the deletion of Penlp1 gene and subtilisin-related peptidase Peprt gene in P. expansum resulted in obvious changes in mycelia morphology and structure, reduction in conidia production, and declined virulence on apple fruits when compared to the wild type, suggesting their important roles in the pathogenicity of P. expansum. Most recently, Blistering1, a protein with DnaJ domain, was identified as virulence factor in P. expansum through a T-DNA mutagenesis screening by Jurick et al. [16], in which they found that knockout of this gene resulted in reduced patulin production, decreased lesion diameter on apples, and impaired protein secretion, especially the extracellular secretion of plant cell-wall-degrading enzymes. However, characterization of effector proteins in P. expansum and investigation of their potential functions in plant infection and disease development have not been accomplished.
With the advent of fungal genome sequencing, omics approaches based on experimental analysis or computational prediction have been widely utilized for high-throughput screening of effector candidates [17,18,19,20]. For instance, through RNA-Seq analysis combined with SignalP prediction, 1728 putative secreted effector protein genes were predicted in Magnaporthe oryzae at 12, 24, 36, and 48 h post inoculation on barley leaves. The MoSVP gene, which encodes a protein with a hydrophobic surface binding protein A domain, was selected, and target deletion of this gene resulted in a reduction in pathogenicity, suggesting that MoSVP is a novel virulence effector of M. oryzae [18]. Therefore, with the aim to identify virulent effectors on a large scale and better characterize the molecular basis for the virulence, we performed transcriptome profiling of P. expansum during plant infection followed by in silico prediction to screen secreted virulence effectors. More specifically, a concanavalin A-like lectin/glucanase (named Peclg) gene, one of the candidate effector protein genes up-regulated in P. expansum during infection of apple fruits, was functionally characterized by gene knockout and revealed that Peclg plays an important role in the virulence of P. expansum.
2. Materials and Methods
2.1. Strains and Growth Conditions
Penicillium expansum (isolate 3.3703) was obtained from China General Microbiological Culture Collection Center and maintained on potato dextrose agar (PDA) medium at 25 °C. For the preparation of conidia, 10 mL sterile water was added to the one-week-old PDA cultures. Conidia were collected by scraping the plates followed by filtration to remove the mycelium and then re-suspended in distilled water to a concentration of 108 conidia per milliliter.
2.2. Scanning Electron Microscopy Observation
Uniform wounds (5 × 5 mm, deep × wide) were made at the equator of apple fruits, and a total of 20 μL P. expansum suspension (106 conidia/mL) was artificially inoculated into each wound [21]. Treated apples were then kept in plastic baskets and covered with film wraps to maintain relative humidity of 90% at storage temperature of 25 °C. At 0, 6, 9, 12, and 24 h after inoculation (hai), fruit disks were prepared by cutting from the edge of lesion. Samples were then fixed in 2.5% glutaraldehyde/0.1 M PBS (pH 7.0) at 4 °C overnight. After the fixation procedure, samples were washed with PBS for three times to remove the extra glutaraldehyde, followed by dehydration in increasing concentrations of ethanol solutions (25%, 50%, 70%, 95%, and 100%). Samples were mounted on specimen stubs, sputter-coated with gold under vacuum, and imaged with a Hitachi S-4800 Field emission scanning electron microscope (Hitachi Medical Corporation, Tokyo, Japan).
2.3. cDNA Library Construction, Sequencing, and Effector Protein Genes Prediction
Samples were collected as above described at 6 and 12 hai for RNA extraction. Total RNA was isolated using Trizol RNA Extraction Kit (SK1321). RNA quality was determined by agarose gel electrophoresis, and RNA quantity was measured using Qubit RNA Assay Kit in Qubit 2.0 Flurometer (Life Technologies, Carlsbad, CA, USA). RNA-Seq libraries were constructed using a VAHTSTM mRNA-seq V2 Library Prep Kit for Illumina (Vazyme Biotech, Nanjing, China) following the manufacturer’s protocol. The preprocessed RNA-Seq reads were then mapped to the reference P. expansum genome (https://www.ncbi.nlm.nih.gov/genome/11336?genome_assembly_id=212204, accessed on 19 May 2022) using TopHat program (v2.0.11).
Transcript abundance was normalized as fragments per kb of transcript sequence per million mapped fragments (FPKM) using Cufflinks (version 2.2.1). Differentially expressed genes (DEGs) were identified using the Cuffdiff v2.2.1, and the threshold was set with fold change ≥ 2.0 and cut-off of false-discovery rate (FDR) p-value < 0.05. Afterwards, GO (gene ontology) enrichment analysis was conducted using Blast2GO program, and KEGG analysis was performed using the online KEGG Automatic Annotation Sever (KAAS, http://www.genome.jp/kegg/kaas/, accessed on 19 May 2022). In silico prediction of secreted protein genes was performed according to Ökmen et al. [22]. In brief, P. expansum secreted protein genes were predicted using the SignalP program (https://services.healthtech.dtu.dk/service.php?SignalP-5.0, accessed on 19 May 2022) to determine the presence of N-terminal signal peptide, and subsequently, TargetP (https://services.healthtech.dtu.dk/service.php?TargetP-2.0, accessed on 19 May 2022) and TMHMM software (https://dtu.biolib.com/DeepTMHMM, accessed on 19 May 2022) program were used to identify and remove proteins predicted to be located at the mitochondrion and membrane.
2.4. Quantitative Real-Time PCR
Total RNA was reverse-transcribed into cDNA in a volume of 20 μL using the First Strand Synthesis Kit (Thermo Fisher Scientific, Waltham, MA, USA), according to the manufacturer’s instructions. qRT-PCR was performed on a StepOne Plus thermocycler (Applied Biosystems, Foster, CA, USA) utilizing SYBR Green Fast qPCR Master Mix (Sangon Biotech, Shanghai, China). The PCR procedure was set as follows: 3 min at 95 °C followed by 45 cycles at 95 °C for 3 s, 60 °C for 30 s, and 72 °C for 30 s. The relative expression level was calculated using the 2−ΔΔCt method, and the 18S rDNA gene was used as a constitutive control. Each sample contains three analytical replicates and two biological replicates (four P. expansum-inoculated apple fruits for each). Primers used in qRT-PCR are listed in Table S1.
2.5. Construction of Peclg Deletion Mutant
Peclg knockout mutant (ΔPeclg) was constructed according to the methods described by Zhang et al. [23], with some modifications. P. expansum genomic DNA was isolated using a Fungi Genomic DNA Isolation Kit (Sangon Biotech, Shanghai, China). The upstream and downstream regions at the target site of Peclg were amplified from genomic DNA of P. expansum using Peclg-up-F/Peclg-up-R and Peclg-down-F/Peclg-down-R primer pairs, respectively. Hygromycin B phosphotransferase (hyg) gene was amplified from a binary vector pCAMBIA-1300 using hyg-F/hyg-R primer pair. The three fragments were fused together to generate the deletion allele of Peclg by overlap PCR using the knockout primer pair Peclg-knock-F/Peclg-knock-R. The resulting deletion allele was then directly introduced into the P. expansum protoplasts using a polyethylene-glycol-mediated transformation. The transformants were cultivated on PDA medium containing 120 μg/mL hygromycin B, and plates were incubated for 3–7 days. Hygromycin-B-resistant colonies were picked and confirmed by PCR amplification using the specific primers Peclg-out-F/Peclg-out-R, which were designed to detect the deletion allele of Peclg gene in the transformants, and Peclg-in-F/Peclg-in-R primers, which was specific to Peclg gene.
2.6. Radial Growth, Conidia Germination, and Chemical Sensitivity Assays
For radial growth assay, an appropriate amount of conidial suspension (10 μL, 107 conidia/mL) of the wild type and deletion mutant strain was inoculated at the center of PDA plate, respectively. After incubation for 7 d at 25 °C, the mycelia colony diameter was measured, and conidia produced on the plate were harvested in sterile distilled water. Conidia were counted using a hemocytometer and converted to the number of conidia per square centimeter of colony.
Conidia germination assay was performed according to Sun et al. [24]. Briefly, 10 μL of conidial suspension (107 conidia/mL) was inoculated in PDB liquid medium. Numbers of germinated conidia were counted microscopically after incubation for 18 h to assess germination rate of conidia. Conidia were considered to be germinated when the germ tube length was greater than the conidia diameter.
For chemical sensitivity tests, the wild type and ΔPeclg mutant were cultured on PDA plate containing 1 M NaCl, 10 mM H2O2, 0.04% SDS and 300 μg/mL Congo red, respectively. The colony diameters were measured after incubation at 25 °C for 7 days, and the percentage of radial growth inhibitions was calculated.
2.7. Patulin Content Determination
Patulin content was determined with high-performance liquid chromatography (HPLC) as described previously [25]. Briefly, 50 mL apple juice medium was inoculated with 1 mL of P. expansum conidial suspension (107 conidia/mL) and incubated at 25 °C in the dark for 3 d. The supernatant was filtrated through filtered through a 0.45 µm filter, followed by extraction with the same volume of ethyl acetate for two times. The collected upper layers were cleaned with 1.5% sodium carbonate and evaporated to dryness using a rotavapor system. The dried residue was dissolved completely with 1 mL of 0.2 mol/L acetic acid, filtered through 0.22 μm membrane filter, and then used for patulin quantification. HPLC analysis was carried out with a Shimadzu SPD-M20A HPLC system (Shimadzu, Kyoto, Japan). Chromatographic separation was achieved using a column of Shim-pack VP-ODS C18 (250 × 4.6 mm, 5 μm) at room temperature. The modified mobile phase, H2O with acetonitrile 90:10 (v/v), was used with a flow rate of 1 mL/min and isocratic mode. The detection wavelength was set at 276 nm. Three replicates (four flasks for each) were used in this assay.
2.8. Virulence Assay
Apple fruits were surface-sterilized in 1% sodium hypochlorite solution for 2 min, rinsed in sterile distilled water three times, and air-dried at room temperature. Then, uniform wounds (5 × 5 mm, deep × wide) were made with a sterile nail around the equator of apple fruits. Artificial infection was performed by inoculating 10 μL conidia suspension (107 conidia/mL) of the ΔPeclg mutant or the wild-type strain of P. expansum in each wound, while control fruits were inoculated with 10 μL sterile distilled water. The treated apple fruits were then kept in the dark at the temperature of 25 °C in a relative humidity of 90% for 9 d. The development of the disease lesions during the storage was examined by measuring two perpendicular diameters. Four apple fruits constituted a single replicate, and each treatment was replicated three times.
2.9. Statistical Analysis
Statistical analyses were performed by using SPSS 16.0 statistic software package (SPSS Inc., Chicago, IL, USA). All the data were expressed as means ± standard deviation (SD), and subjected to one-way ANOVA with Duncan’s multiple-range tests. Differences were considered statistically significant for p < 0.05.
3. Results
3.1. Microscopy Observation of P. expansum during Plant Infection
Scanning electronic microscopy was used to observe the infection process of P. expansum in apple fruits. As shown in Figure 1, the conidia of the P. expansum were elliptical in shape with a diameter of 3~5 μm and swelled at 6 hai. It was already possible to notice the conidial germination and the penetration of elongated germ-tubes through the apple tissues at 9 hai. Meanwhile, a layer of mesh-like substances secreted by fungal cells could be seen at the surface of wounds, which might facilitate the penetration. After 12 and 24 hai, the pulp of apple tissues began to undergo degradation due to the increased mycelium quantity in this region. It has been well-documented that production of effector proteins is a survival strategy for pathogens to overcome or inactivate the host immune response, resulting in progression of pathogenesis particularly at the early stage of infection [26]. Therefore, based on these findings, samples were collected at 6 and 9 hai and subjected to transcriptome analysis of P. expansum during the infection progress with the aim to identify the candidate effector genes.

Figure 1.
Scanning electron micrographs of Penicillium expansum-infected apple tissues at different time points.
3.2. Transcriptome Analysis of P. expansum during Plant Infection
cDNA libraries from P. expansum-infected fruit tissues at 0, 6, and 9 hai were generated and obtained a total of 85.6 Gb of sequence data composed of 285,211,054 clean reads. From these, 0.62%, 13.85%, and 18.01% of the cleaned reads in 0, 6, and 9 hai samples, respectively, were mapped to the genome of P. expansum (Table S2). RNA-Seq analysis yielded 3255 differentially expressed genes (DEGs) with fold change ≥2 at 6 hai, with 2462 up-regulated and 793 down-regulated, and 3824 DEGs at 9 hai, with 3046 upregulated and 778 down regulated (Figure 2a and Table S3). To validate gene expression profile, eight DEGs were randomly selected for qRT-PCR analysis. As illustrated in Figure 2b, the expression patterns of these eight genes were generally consistent with the results obtained by RNA-Seq (r2 = 0.76), confirming the accuracy and reliability of the data from RNA-Seq. Further gene ontology (GO) and Kyoto Encyclopedia of Genes and Genomes (KEGG) enrichment analyses of P. expansum DEGs indicated that the enriched GO terms (Figure S1) and KEGG pathways (Figure S2) of the DEGs were similar to those previously reported [27,28].

Figure 2.
RNA-Seq analysis of Penicillium expansum during infection of apple fruits. (a) Volcano plot of all DEGs in Penicillium expansum at 6 and 9 hai. The red and green spots represent the up-regulated and down-regulated genes, respectively. (b) qRT-PCR validation of RNA-Seq data.
Fungal effector genes are specifically expressed during the infection stage, and most of the effector proteins were secreted via the classical endoplasmic reticulum secretory pathway, which involves an N-terminal signal peptide [29]. Therefore, in silico prediction was used to identify effector candidate genes in the set of up-regulated genes during the infection of P. expansum on apple fruit, yielding 212 and 268 secreted effector protein genes at 6 and 9 hai, respectively (Table S4). In addition to a number of unknown-function proteins, as expected, a significant portion of the secreted proteins with biological function was enzyme, mainly including the glycosyl hydrolase family, lipase, peptidases, oxidoreductases, and nuclease.
It is worth noticing that a number of secreted protein genes were identified as cell-wall-degrading enzymes, including concanavalin A-like lectin/glucanases (PEX2_021580, PEX2_031290, and PEX2_080610), pectin lyase (PEX2_016450, PEX2_031470, and PEX2_107230), pectinesterase (PEX2_013190), and a number of glycoside hydrolase members (PEX2_000950, PEX2_003900, PEX2_016600, and PEX2_097510), and many efforts have been made on members of this family for their potential role as virulence factors [30,31,32]. In this study, a concanavalin A-like lectin/glucanase gene (PEX2_031290, denoted as Peclg) was dramatically induced during the pathogen–host interaction. Therefore, we conducted further research focusing the on Peclg gene. To characterize the function of Peclg in P. expansum, the Peclg knockout mutants (ΔPeclg) with a hygromycin-resistance gene instead of the entire Peclg gene were constructed by homologous recombination (Figure S3).
3.3. Peclg Is Involved in Fungal Growth, Patulin Production, and Chemical Sensitivity
To reveal the possible roles of Peclg in fungal growth and development, the radial growth, conidial production, and germination of the ΔPeclg mutant and wild type were also analyzed. As presented in Figure 3a, the ΔPeclg mutant grew more rapidly than the wild type on PDA plate. After 7 d of growth, the colony diameter of the wild type was 4.0 cm, whereas the colony diameter of ΔPeclg mutant reached 4.9 cm. Meanwhile, visual assessments showed that the mycelia of ΔPeclg mutant appeared lighter in color and much looser. Moreover, the conidia production of the ΔPeclg mutant on PDA plate was 0.6 × 105 conidia/mm2, which is significantly lower than 1.5 × 105 conidia/mm2 of the wild-type strain (Figure 3b). After 10 h of incubation, about 59.7% of ΔPeclg conidia were germinated compared to 72.3% of the wild-type conidia, indicating a slight reduce in conidia germination rate (Figure 3c). When the patulin production abilities were evaluated, no significant difference was observed between the wild type and the ΔPeclg mutant (data not shown).

Figure 3.
Effects of Peclg gene on (a) radial growth, (b) conidial production, and (c) germination of Penicillium expansum. Data are presented as means ± SD of three replicates. Asterisks indicate statistically significant differences (p < 0.05) between strains.
To further investigate whether the Peclg is required for the adaptation of P. expansum to chemical stresses, the ΔPeclg mutant and wild type were incubated on PDA plate amending with different chemical reagents. As illustrated in Figure 4, the ΔPeclg mutant showed more sensitive to osmotic (NaCl) and cell wall (SDS and Congo red) stresses compared to the wild type; however, no significant difference was observed among them when exposed to oxidative (H2O2) stress. All these results indicated that the Peclg gene might be involved in the response to osmotic stress and is required to maintain the cell wall integrity.

Figure 4.
The Peclg gene regulates chemical stress responses in Penicillium expansum. (a) Colony morphology of the wild-type and ΔPeclg strains grown on PDA plate containing 1 M NaCl, 10 mM H2O2, 0.04% SDS, and 300 μg/mL Congo red. (b) Inhibition rate of growth in different stress treatments. The experiments were performed with three biological replicates. Data are presented as means ± SD of three replicates. Asterisks indicate statistically significant differences (p < 0.05) between strains.
3.4. Peclg Plays Important Role in the Virulence of P. expansum
To explore whether the Peclg gene is required for the virulence of P. expansum, pathogenicity tests on apple fruits were performed for the wild-type and ΔPeclg strains. Conidial suspensions of the wild-type and mutant strains were artificially inoculated on apple fruits, and then, the lesion diameter was measured after inoculation. As shown in Figure 5a, both wild-type and ΔPeclg strains induced disease on apple fruits. However, the diameter of disease lesion caused by the ΔPeclg strain was obviously smaller compared to that caused by the wild-type P. expansum, indicating a 25.5% reduction in lesion diameter 7 days after inoculation (Figure 5b).

Figure 5.
Blue mold lesions on apple fruits caused by the wild-type and ΔPeclg strain of Penicillium expansum 7 d after inoculation (dai) (a) and a graphical presentation of the lesion diameter at 3, 5, and 7 dai (b). Data are presented as means ± SD of three replicates, and each replicate contains four apples. Asterisks indicate statistically significant differences (p < 0.05) between strains.
4. Discussion
Fungal pathogen secreted vast arrays of effector proteins during infection to aid in host colonization. Hence, the identification of virulence-related effector protein genes and functional characterization of their roles are critical for understanding the molecular mechanisms behind the pathogen–host plant interaction. In the present study, transcriptomic analyses of P. expansum during infection of apple fruits were performed, and a total of 212 and 268 candidate effector genes were identified at 6 and 9 hai, respectively. One of the effector genes was identified as Peclg, which was dramatically induced during the pathogen–host interaction. Therefore, further characterization of Peclg was performed to explore its potential roles in the infection and development of P. expansum decay on apples.
Concanavalin A-like lectin/glucanase, which belongs to glycoside hydrolase family and exhibits carbohydrate binding and glucanase activity, is known to be involved in various biological processes, such as morphogenesis, cell wall growth and extension, and suppression or prevention of plant immune responses [33,34]. As reported in the present work, target deletion of Peclg in P. expansum resulted in increased mycelial growth and reduced conidial production and germination relative to the wild type. Similar to our results, decreased conidial production was observed in knockout studies of glucanase gene in Cochliobolus carbonum [35] and Pyrenophora tritici-repentis [36]; however, the deletion of glucanase gene in these fungi also resulted in reduced growth rate, which was inconsistent with the ΔPeclg mutant. These data clearly indicated an important role of Peclg in regulating fungal growth and development; moreover, this regulation might be a species-dependent process, and further studies are needed to investigate the potential underlying mechanisms related to this regulation.
The sensitivity of the ΔPeclg mutant to some chemicals was also evaluated, and the results revealed that the ΔPeclg mutant showed defects in cell wall integrity because it showed increased sensitivity to cell-wall-destabilizing agents. It is reasonable since glucan is the main component of the fungal cell wall, and glucanase as well as other glucosidases are known to be essential for cell wall glucan synthesis and modification [37]. In Saccharomyces cerevisiae, the function of an endoglucanase gene (Scw10) was characterized by gene knockout, and deletion of the corresponding gene caused additive sensitivity towards cell wall stresses, suggesting a role in cell wall assembly or maintenance [38]. Similar results were also reported in Neurospora crassa, as endo-1,6-β-D-glucanase (neg1) gene deletion mutant does not affect fungal morphology but displayed no obvious phenotypic changes, but Congo-red and SDS, which affect fungal cell walls or membranes, remarkably inhibited the hyphal growth of the mutant at a concentration that did not inhibit growth in the wild type [39].
The plant cell wall provides the first physical barrier to prevent pathogen infection, and pathogens secrete numerous cell-wall-degrading enzymes, such as glucanases, galacturonases, and pectin lyases, that might contribute to the evading plant innate immune recognition and enable the penetration and spread within the host plant tissues by directly participating in the degradation of plant cell wall components, thereby playing an important role in the mechanisms of virulence during the entire infection cycle of the pathogen [36,40,41]. For instance, Fu et al. [35] found that knockout of GLU1 gene in Pyrenophora tritici-repentis, the major causal agent of wheat tan spot, resulted in a significantly reduced virulence, with a reduction up to 37% in diseased leaf area. Further cytological analysis of the infection revealed that the mutant produced significantly lower numbers of germ tubes and appressoria than the wild-type strain on susceptible wheat leaves. Another well-studied example is PsXEG1, a secreted protein from Phytophthora sojae, which exhibits xyloglucanase and β-glucanase activity and acts as an important effector during P. sojae infection but also acts as a pathogen-associated molecular pattern in soybean, where it can trigger defense responses including cell death [42]. Very recently, Ökmen et al. [32] functionally characterized Erc1, a conserved effector of smut fungus Ustilago maydis with an organ-specific virulence function in maize leaves. Their work also found that Erc1 binds to host cell wall components, displays 1,3-β-glucanase activity, and prevents β-glucan-induced host defenses, which is required for cell-to-cell extension, specifically in bundle sheaths cells. Moreover, although some research reported that patulin might play an important but not essential role in the pathogenicity of P. expansum [6,43,44], no significant difference in patulin production was observed between the wild type and ΔPeclg in this work, indicating that the reduced virulence of ΔPeclg is not due to its patulin production ability.
5. Conclusions
In this study, using a combination of transcriptome analysis of P. expansum during infection of apple fruits and in silico prediction, a large number of effector gene candidates were identified. A high proportion of the identified effector candidates were cell-wall-degrading enzyme genes, including concanavalin A-like lectin/glucanases, pectin lyase, and pectinesterase. A novel effector gene candidate, Peclg, was selected for functional characterization, and the results revealed that Peclg plays important roles in conidial production, germination, and the responses to environmental stresses. Moreover, target knockout of the Peclg gene also resulted in reduced virulence of P. expansum in apple fruits. All these findings suggested that Peclg functions as an important determinant of fungal growth, development, and virulence in P. expansum.
Supplementary Materials
The following supporting information can be downloaded at: https://www.mdpi.com/article/10.3390/foods12030479/s1, Figure S1: Gene ontology (GO) categorization of DEGs in P. expansum during the early stage of infection on apple fruits. (a) 6 hai and (b) 9 hai. GO analysis was performed for three main categories: cellular component, molecular function and biological process. title; Figure S2: Statistics of Kyoto Encyclopedia of Genes and Genomes (KEGG) pathway enrichment analysis of DEGs in P. expansum during the early stage of infection on apple fruits. (a) 6 hai and (b) 9 hai. KEGG pathways are plotted on the ordinate, and the enrichment factor (rich factor) is plotted on the abscissa. The size of points represents the number of DEGs mapped to the reference pathway, and the color of points represents the q-value. Figure S3: Construction and identification of ΔPeclg mutant. (a) Schematic diagram of Peclg knockout strategy. (b) Amplification of upstream, downstream and hyg fragments. (c) Fusion fragment obtained by overlap PCR amplification. (d) Verification of ΔPeclg by PCR amplification using in and out primer pairs; Table S1: Primers used in qRT-PCR; Table S2: Summary of the RNA-Seq data and the reads mapped to P. expansum genome; Table S3: Differentially expressed genes in P. expansum at 6 and 9 hai; Table S4: List of the predicted effector protein genes in P. expansum at 6 and 9 hai.
Author Contributions
Conceptualization, X.Z. and Y.W.; methodology, W.G. and X.X.; investigation, J.Z. (Jiayu Zhou), T.T. and J.Z. (Jiaqi Zhang); writing—original draft preparation, J.Z. (Jiayu Zhou); writing—review and editing, L.Z. and X.Z.; supervision, X.Z. and Y.W.; funding acquisition, Y.W. All authors have read and agreed to the published version of the manuscript.
Funding
This research was supported by National Natural Science Foundation of China (32072639).
Institutional Review Board Statement
Not applicable.
Data Availability Statement
Data are contained within the article and supplementary materials.
Conflicts of Interest
The authors declare no conflict of interest.
References
- Pal, S.; Singh, N.; Ansari, K.M. Toxicological effects of patulin mycotoxin on the mammalian system: An overview. Toxicol. Res. 2017, 6, 764–771. [Google Scholar] [CrossRef] [PubMed]
- Saleh, I.; Goktepe, I. The characteristics, occurrence, and toxicological effects of patulin. Food Chem. Toxicol. 2019, 129, 301–311. [Google Scholar] [CrossRef] [PubMed]
- Yan, H.J.; Gaskins, V.L.; Vico, I.; Luo, Y.G.; Jurick, W.M. First report of Penicillium expansum isolates resistant to pyrimethanil from stored apple fruit in Pennsylvania. Plant Dis. 2014, 98, 1004. [Google Scholar] [CrossRef] [PubMed]
- Gaskins, V.L.; Vico, I.; Yu, J.; Jurick, W.M. First report of Penicillium expansum isolates with reduced sensitivity to fludioxonil from a commercial packinghouse in Pennsylvania. Plant Dis. 2015, 99, 1182. [Google Scholar] [CrossRef]
- Ballester, A.R.; Houben, M.; Levin, E.; Sela, N.; Lazaro, C.S.; Carmona, L.; Wisniewski, M.; Droby, S.; Gonzalez-Candelas, L.; Gabaldon, T. Genome, transcriptome, and functional analysis of Penicillium expansum provide new insights into secondary metabolism and pathogenicity. Mol. Plant-Microbe Interact. 2015, 28, 232–248. [Google Scholar] [CrossRef] [PubMed]
- Li, B.; Zong, Y.; Du, Z.; Chen, Y.; Zhang, Z.; Qin, G.; Zhao, W.; Tian, S. Genomic characterization reveals insights into patulin biosynthesis and pathogenicity in Penicillium species. Mol. Plant-Microbe Interact. 2015, 28, 635–647. [Google Scholar] [CrossRef]
- Wenneker, M.; Thomma, B.P.H.J. Latent postharvest pathogens of pome fruit and their management: From single measures to a systems intervention approach. Eur. J. Plant Pathol. 2020, 156, 663–681. [Google Scholar] [CrossRef]
- Prusky, D.; Lichter, A. Activation of quiescent infections by postharvest pathogens during transition from the biotrophic to the necrotrophic stage. FEMS Microbiol. 2007, 268, 1–8. [Google Scholar] [CrossRef]
- Horbach, R.; Navarro-Quesada, A.R.; Knogge, W.; Deising, H.B. When and how to kill a plant cell: Infection strategies of plant pathogenic fungi. J. Plant Physiol. 2011, 168, 51–62. [Google Scholar] [CrossRef]
- Wang, Y.; Pruitt, R.N.; Nurnberger, T.; Wang, Y. Evasion of plant immunity by microbial pathogens. Nat. Rev. Microbiol. 2022, 20, 449–464. [Google Scholar] [CrossRef]
- Selin, C.; de Kievit, T.R.; Belmonte, M.F.; Fernando, W.G.D. Elucidating the role of effectors in plant-fungal interactions: Progress and challenges. Front. Microbiol. 2016, 7, 600. [Google Scholar] [CrossRef] [PubMed]
- de Moraes Pontes, J.G.; Fernandes, L.S.; Santos, R.V.; Tasic, L.; Fill, T.P. Virulence factors in the phytopathogen-host interactions: An overview. J. Agric. Food Chem. 2020, 68, 7555–7570. [Google Scholar] [CrossRef] [PubMed]
- Luciano-Rosario, D.; Keller, N.P.; Jurick, W.M. Penicillium expansum: Biology, omics, and management tools for a global postharvest pathogen causing blue mould of pome fruit. Mol. Plant Pathol. 2020, 21, 1391–1404. [Google Scholar] [CrossRef]
- Levin, E.; Kishore, A.; Ballester, A.R.; Raphael, G.; Feigenberg, O.; Liu, Y.; Norelli, J.; Gonzalez-Candelas, L.; Wisniewski, M.; Droby, S. Identification of pathogenicity-related genes and the role of a subtilisin-related peptidase S8 (PePRT) in authophagy and virulence of Penicillium expansum on apples. Postharvest Biol. Technol. 2019, 149, 209–220. [Google Scholar] [CrossRef]
- Levin, E.; Raphael, G.; Ma, J.; Ballester, A.R.; Feygenberg, O.; Norelli, J.; Aly, R.; Gonzalez-Candelas, L.; Wisniewski, M.; Droby, S. Identification and functional analysis of NLP-encoding genes from the postharvest pathogen Penicillium expansum. Microorganisms 2019, 7, 175. [Google Scholar] [CrossRef]
- Jurick, W.M.; Peng, H.; Beard, H.S.; Garrett, W.M.; Lichtner, F.J.; Luciano-Rosario, D.; Macarisin, O.; Liu, Y.; Peter, K.A.; Gaskins, V.L.; et al. Blistering1 modulates Penicillium expansum virulence via vesicle-mediated protein secretion. Mol. Cell. Proteomics 2020, 19, 344–361. [Google Scholar] [CrossRef] [PubMed]
- de Carvalho, M.C.D.G.; Nascimento, L.C.; Darben, L.M.; Polizel-Podanosqui, A.M.; Lopes-Caitar, V.S.; Qi, M.; Rocha, C.S.; Carazzolle, M.F.; Kuwahara, M.K.; Pereira, G.A.G.; et al. Prediction of the in planta Phakopsora pachyrhizi secretome and potential effector families. Mol. Plant Pathol. 2017, 18, 363–377. [Google Scholar] [CrossRef]
- Shimizu, M.; Nakano, Y.; Hirabuchi, A.; Yoshino, K.; Kobayashi, M.; Yamamoto, K.; Terauchi, R.; Saitoh, H. RNA-Seq of in planta-expressed Magnaporthe oryzae genes identifies MoSVP as a highly expressed gene required for pathogenicity at the initial stage of infection. Mol. Plant Pathol. 2019, 20, 1682–1695. [Google Scholar] [CrossRef]
- Elmore, M.G.; Banerjee, S.; Pedley, K.F.; Ruck, A.; Whitham, S.A. De novo transcriptome of Phakopsora pachyrhizi uncovers putative effector repertoire during infection. Physiol. Plant Mol. Pathol. 2020, 110, 101464. [Google Scholar] [CrossRef]
- Soria, N.W.; Badariotti, E.H.; Alasino, V.R.; Figueroa, A.C.; Diaz, M.S.; Yang, P.; Beltramo, D.M. Elucidating potential effectors, pathogenicity and virulence factors expressed by the phytopathogenic fungus Thecaphora frezii through analysis of its transcriptome. Eur. J. Plant Pathol. 2022, 164, 325–335. [Google Scholar] [CrossRef]
- Li, H.; Wang, Y.; Liu, F.; Yang, Y.; Wu, Z.; Cai, H.; Zhang, Q.; Wang, Y.; Li, P. Effects of chitosan on control of postharvest blue mold decay of apple fruit and the possible mechanisms involved. Sci. Hortic. 2015, 186, 77–83. [Google Scholar] [CrossRef]
- Ökmen, B.; Mathow, D.; Hof, A.; Lahrmann, U.; Assmann, D.; Doehlemann, G. Mining the effector repertoire of the biotrophic fungal pathogen Ustilago hordei during host and non-host infection. Mol. Plant Pathol. 2018, 19, 2603–2622. [Google Scholar] [CrossRef] [PubMed]
- Zhang, J.; Meng, D.; Xia, X.; Sun, Y.; Zhao, L.; Zhou, X.; Wang, Y. Profiling the secretomes of Penicillium expansum reveals that a serine carboxypeptidase (PeSCP) is required for the fungal virulence on apple fruit. Physiol. Mol. Plant Pathol. 2022, 122, 101897. [Google Scholar] [CrossRef]
- Sun, Y.; Shang, L.; Xia, X.; Meng, D.; Ren, Y.; Zhang, J.; Yao, M.; Zhou, X.; Wang, Y. Cellular uptake of chitosan and its role in antifungal action against Penicillium expansum. Carbohyd. Polym. 2020, 269, 118349. [Google Scholar] [CrossRef] [PubMed]
- Ren, Y.; Yao, M.; Chang, P.; Sun, Y.; Li, R.; Meng, D.; Xia, X.; Wang, Y. Isolation and characterization of a Pseudomonas poae JSU-Y1 with patulin degradation ability and biocontrol potential against Penicillium expansum. Toxicon 2021, 195, 1–6. [Google Scholar] [CrossRef] [PubMed]
- Ellis, J.G.; Rafiqi, M.; Gan, P.; Chakrabarti, A.; Dodds, P.N. Recent progress in discovery and functional analysis of effector proteins of fungal and oomycete plant pathogens. Curr. Opin. Plant Biol. 2009, 12, 399–405. [Google Scholar] [CrossRef]
- Wang, K.; Zheng, X.; Zhang, X.; Zhao, L.; Yang, Q.; Boateng, N.A.S.; Ahima, J.; Liu, J.; Zhang, H. Comparative transcriptomic analysis of the interaction between Penicillium expansum and apple fruit (Malus pumila Mill.) during early stages of infection. Microorganisms 2019, 7, 495. [Google Scholar] [CrossRef]
- Xu, M.; Yang, Q.; Boateng, N.A.S.; Ahima, J.; Dou, Y.; Zhang, H. Ultrastructure observation and transcriptome analysis of Penicillium expansum invasion in postharvest pears. Postharvest Biol. Technol. 2020, 165, 111198. [Google Scholar] [CrossRef]
- Rafiqi, M.; Ellis, J.G.; Ludowici, V.A.; Hardham, A.R.; Dodds, P.N. Challenges and progress towards understanding the role of effectors in plant-fungal interactions. Curr. Opin. Plant Biol. 2012, 15, 477–482. [Google Scholar] [CrossRef]
- Gui, Y.; Chen, J.; Zhang, D.; Li, N.; Li, T.; Zhang, W.; Wang, X.; Short, D.P.G.; Li, L.; Guo, W.; et al. Verticillium dahliae manipulates plant immunity by glycoside hydrolase 12 proteins in conjunction with carbohydrate-binding module 1. Envrion. Microbiol. 2017, 19, 1914–1932. [Google Scholar] [CrossRef]
- Ramzi, A.B.; Me, M.L.C.; Ruslan, U.S.; Baharum, S.N.; Muhammad, N.A.N. Insight into plant cell wall degradation and pathogenesis of Ganoderma boninense via comparative genome analysis. PeerJ 2020, 7, e8065. [Google Scholar] [CrossRef] [PubMed]
- Ökmen, B.; Jaeger, E.; Schilling, L.; Finke, N.; Klemd, A.; Lee, Y.J.; Wemhoner, R.; Pauly, M.; Neumann, U.; Doehlemann, G. A conserved enzyme of smut fungi facilitates cell-to-cell extension in the plant bundle sheath. Nat. Comm. 2022, 13, 6003. [Google Scholar] [CrossRef] [PubMed]
- Martin, K.; McDougall, B.M.; McIlroy, S.; Chen, J.; Seviour, R.J. Biochemistry and molecular biology of exocellular fungal β-(1,3)- and β-(1,6)-glucanases. FEMS Microbiol. Rev. 2007, 31, 168–192. [Google Scholar] [CrossRef] [PubMed]
- Bradley, E.L.; Okmen, B.; Doehlemann, G.; Henrissat, B.; Bradshaw, R.E.; Mesarich, C.H. Secreted glycoside hydrolase proteins as effectors and invasion patterns of plant-associated fungi and oomycetes. Front. Plant Sci. 2022, 13, 853106. [Google Scholar] [CrossRef] [PubMed]
- Kim, H.; Ahn, J.H.; Gorlach, J.M.; Caprari, C.; Scott-Craig, J.S.; Walton, J.D. Mutational analysis of β-glucanase genes from the plant pathogenic fungus Cochliobolus carbonum. Mol. Plant-Microbe Interact. 2001, 14, 1436–1443. [Google Scholar] [CrossRef] [PubMed]
- Fu, H.; Feng, J.; Aboukhaddour, R.; Cao, T.; Hwang, S.; Strelkov, S.E. An exo-1,3-beta-glucanase GLU1 contributes to the virulence of the wheat tan spot pathogen Pyrenophora tritici-repentis. Fungal Biol. 2013, 117, 673–681. [Google Scholar] [CrossRef] [PubMed]
- Smits, G.J.; van den Ende, H.; Klis, F.M. Differential regulation of cell wall biogenesis during growth and development in yeast. Microbiology 2001, 147, 781–794. [Google Scholar] [CrossRef]
- Sestak, S.; Hagen, I.; Tanner, W.; Strahl, S. Scw10p, a cell-wall glucanase/transglucosidase important for cell-wall stability in Saccharomyces cerevisiae. Microbiology 2004, 150, 3197–3208. [Google Scholar] [CrossRef]
- Oyama, S.; Inoue, H.; Yamagata, Y.; Nakajima, T.; Abe, K. Functional analysis of an endo-1,6-β-D-glucanase gene (neg-1) from Neurospora crassa. Biosci. Biotechnol. Biochem. 2006, 70, 1773–1775. [Google Scholar] [CrossRef]
- Kubicek, C.P.; Starr, T.L.; Glass, N.L. Plant cell wall-degrading enzymes and their secretion in plant pathogenic fungi. Annu. Rev. Phytopathol. 2014, 52, 427–451. [Google Scholar] [CrossRef]
- Nakajima, M.; Akutsu, K. Virulence factors of Botrytis cinerea. J. Gen. Plant Pathol. 2014, 80, 15–23. [Google Scholar] [CrossRef]
- Ma, Z.; Song, T.; Zhu, L.; Ye, W.; Wang, Y.; Shao, Y.; Dong, S.; Zhang, Z.; Dou, D.; Zheng, X.; et al. A Phytophthora sojae glycoside hydrolase 12 protein is a major virulence factor during soybean infection and is recognized as a PAMP. Plant Cell 2015, 27, 2057–2072. [Google Scholar] [CrossRef] [PubMed]
- Barad, S.; Espeso, E.A.; Sherman, A.; Prusky, D. Ammonia activates pacC and patulin accumulation in an acidic environment during apple colonization by Penicillium expansum. Mol. Plant Pathol. 2016, 17, 727–740. [Google Scholar] [CrossRef] [PubMed]
- Kumar, D.; Barad, S.; Chen, Y.; Luo, X.; Tannous, J.; Dubey, A.; Matana, N.G.; Tian, S.; Li, B.; Keller, N.; et al. LaeA regulation of secondary metabolism modulates virulence in Penicillium expansum and is mediated by sucrose. Mol. Plant Pathol. 2017, 18, 1150–1163. [Google Scholar] [CrossRef] [PubMed]
Disclaimer/Publisher’s Note: The statements, opinions and data contained in all publications are solely those of the individual author(s) and contributor(s) and not of MDPI and/or the editor(s). MDPI and/or the editor(s) disclaim responsibility for any injury to people or property resulting from any ideas, methods, instructions or products referred to in the content. |
© 2023 by the authors. Licensee MDPI, Basel, Switzerland. This article is an open access article distributed under the terms and conditions of the Creative Commons Attribution (CC BY) license (https://creativecommons.org/licenses/by/4.0/).